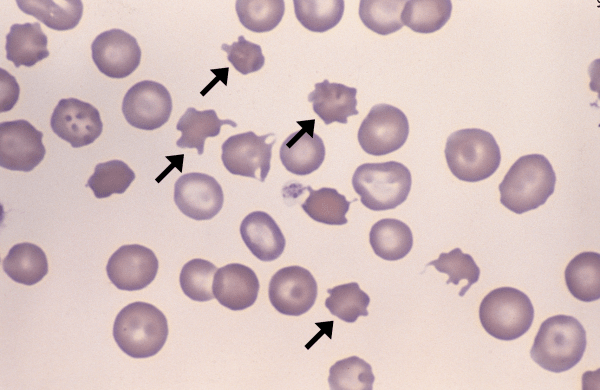

Lymphoid neoplasia is the most common form of hematopoeitic neoplasia in domestic animals. Lymphoid neoplasia can be categorized as lymphosarcomas (neoplastic lymphocytes from solid tumors in extramedullary tissue) or leukemias (neoplastic lymphocytes… Read more Lymphocytic Leukemias →

Morphology: granulocyte with a segmented (often bi-lobed) nucleus and numerous pink-to-orange (eosinophilic) cytoplasmic granules. Considerable species variation in number, size, and shape of eosinophil granules. Considerable variation within and between dog… Read more Eosinophils →

Morphology: red blood cells with irregular spicules projecting from the cell surface. Spicules are variable in shape (blunt or bulbous tips), variable in size, and unevenly distributed around the periphery of… Read more Acanthocytes →